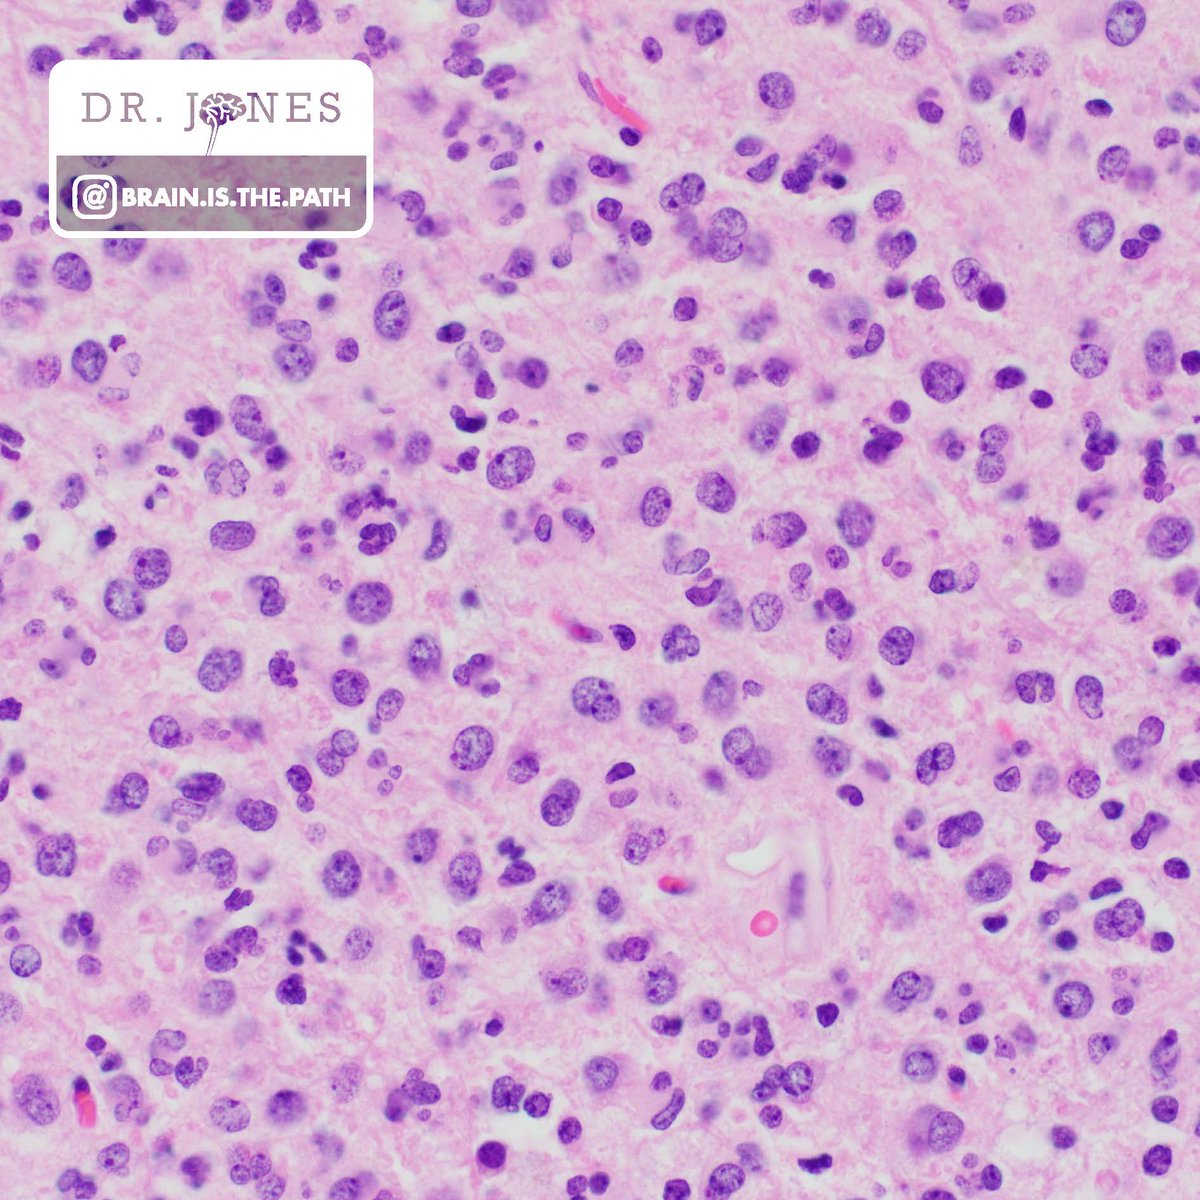
Frontal lobe mass in adult. How would you work it up?

1. H&amp;E differential?
2. IHC to order?
3. Molecular to order?

#neuropath #PathResidents <a href="/UIPathology/">University of Iowa Pathology</a> <a href="/neuropathology/">AANP</a> @kylesconway <a href="/Path_InSitu/">drMoh</a> <a href="/DrMikeLMiller/">Michael L Miller, MD, PhD</a> <a href="/thebigcobb/">Rachael Vaubel</a> <a href="/astroade/">Astroade</a> <a href="/PathologySayah/">Maryam Sayah, MD</a> <a href="/JaredAhrendsen/">Jared T. Ahrendsen MD, PhD (AP/NP/FP)</a>

Abdullah Al-Bouri MD
@ahbouri_md
AP/CP Pathology Residency at WVUMedicine
Now a Cytopathology Fellow at AGH, Pittsburgh
ID: 929189897411399680
11-11-2017 03:31:49
19 Tweet
98 Takipçi
58 Takip Edilen

Frontal lobe mass in adult. How would you work it up? 1. H&E differential? 2. IHC to order? 3. Molecular to order? #neuropath #PathResidents University of Iowa Pathology AANP @kylesconway drMoh Michael L Miller, MD, PhD Rachael Vaubel Astroade Maryam Sayah, MD Jared T. Ahrendsen MD, PhD (AP/NP/FP)

#ASCyto2019 day one has been GREAT. Amazing speakers (Zubair Baloch WC Faquin, MD, PhD #EstherDRossi #DavidLieu Emilio Madrigal, DO), great topics and great local food (RedIguanaRestaurants and #curryfriedchicken 👍🏽👍🏽). PGY3 Andrew Plata ‘s poster is up. #cytologyrocks


Kudos to Andrew Plata for his awesome poster on the WVU Pathology, Anatomy, and Laboratory Medicine experience with Molecular Alterations in Pancreatic Cyst Fluid! #ASCyto19 #cytorocks


Resident Abdullah Al-Bouri MD at the ultrasound #FNA clinic this morning with Ron Balassanian and the rest of the UCSF Cytopathology team. Thanks so much. #ASCyto2019 #ASCyto19 #cytologyrocks


A great experience #ASCyto19 in Salt Lake City. Learned alot and enjoyed my time with great friends Andrew Plata @AliAl-habib. Waiting for #ASCyto20 in Orlando.



Great shot of past and present residents @Dr_Mahenaz_NAZA and Abdullah Al-Bouri MD attending future resident (🤞🏽) @arosescholl ‘s poster presentation. #USCAP2020 #pathology #medstudenttwitter






We here WVU Pathology, Anatomy, and Laboratory Medicine are proud and happy to welcome our incoming residents! And we’d also like to send a big congratulations to all who matched! #VirtualPathMatch #virtualmatchday #pathology #MedStudentTwitter


Very nice case 🤩 spot diagnosis🥳🥳🥳 lung cyst 🤞🏻🤞🏻🤞🏻Pembe Oltulu, MD Kemal Kösemehmetoğlu Jerad Gardner, MD Jonhan Ho Güliz Akdaş Barkan kemal bakir Betül Ünal



It’s #MatchDay2021 and at West Virginia University we are happy to announce the PGY-1 pathology members of the 2021-2025 class. Congratulations future mountaineers and welcome to almost heaven! ☁️☁️ WVU School of Medicine Huda Elzahrany MD Larry Olapeju MD ‘Larry’ Olapeju, MD Yodsui Hernandez MD





